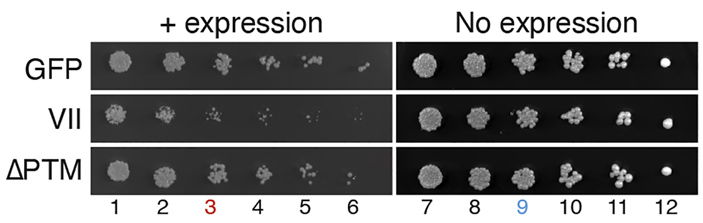
Рис. 3. Белок VII аденовируса подавляет деление клеток дрожжей

Попав в клетку, вирус стремится заставить ее молекулярные машины работать на себя, чтобы они воспроизводили его копии. Происходит это разными путями, но вирусы так или иначе влияют на клеточный цикл своей жертвы. Многие вирусы — в том числе коронавирусы и аденовирусы человека — блокируют клеточное деление. В недавней статье, опубликованной в журнале Current Biology, подробно описан механизм, которым для этого пользуются аденовирусы. Авторы показали, что белок VII, упаковывающий ДНК-геном аденовируса, проявляет гистоноподобные свойства. Он взаимодействует с хроматином клетки и при участии клеточных белков SET и HMGB вытесняет из него компактизующий линкерный гистон H1. Это приводит к разрыхлению хроматина и остановке деления клетки.
Цель любого вируса, сумевшего проникнуть в клетку, состоит в том, чтобы так или иначе заставить клетку служить своим интересам, а именно — обеспечивать вирус всем необходимым для репликации и сборки новых вирионов. Конечно, вирус заинтересован в том, чтобы клетка направляла все свои ресурсы исключительно на нужды вируса. Способы, которыми вирусы «перепрограммируют» клетки, могут быть самыми разными, но в деталях многие из них пока не известны. В недавней статье, опубликованной в журнале Current Biology, подробно описан способ, которым пользуются аденовирусы человека. Авторы обнаружили, что в своей ДНК аденовирусы несут ген, кодирующий белок, который вызывает реорганизацию хроматина клетки-хозяина и блокирует ее клеточный цикл, не давая клетке поделиться.
В поддержании структуры хроматина в клетке участвует множество белков. ДНК в клеточном ядре не находится в свободном виде: она «намотана» на «катушки» из специальных белков — гистонов Одна «катушка» представляет собой октамер из гистонов H2A, H2B, H3 и H4, каждый из которых представлен в «катушке» двумя молекулами. В тех случаях, когда ДНК необходимо «оголить» (например, при репликации или запуске транскрипции), специальные белки временно убирают гистоны с ДНК, а затем возвращают их на место. Совокупность ДНК и связанных с ней гистонов называют хроматином.
На некоторых этапах клеточного цикла необходимо, чтобы генетический материал клетки физически занимал как можно меньше места — например, при делении, когда необходимо растащить хромосомы по дочерним клеткам. В процессе повышения плотности упаковки (компактизации) хроматина, как и в обратном процессе (декомпактизации), участвует множество белковых факторов. Так, линкерный гистон H1 обеспечивает компактизацию хроматина, а белки семейства HMG (High-Mobility Group), наоборот, способствуют декомпактизации хроматина и повышают доступность ДНК для взаимодействия с другими белками. Поскольку гистон H1 и белки HMG обладают противоположной активностью в отношении структуры хроматина, для их правильной и согласованной работы необходима тонкая регуляция, а нарушение этого шаткого равновесия чревато сбоями во множестве клеточных процессов, в том числе и в делении. В обсуждаемой работе показано, что аденовирус спутывает клетке все карты именно за счет воздействия на равновесие между гистоном H1 и белками HMG.
Поскольку большинство разновидностей аденовируса поражают верхние дыхательные пути, авторы исследования моделировали взаимодействие аденовируса с клеткой-хозяином на культуре клеток легочного эпителия человека.
Жизненный цикл аденовируса начинается со связывания вирусных частиц с белками-рецепторами на клеточной мембране. Комплекс аденовируса и рецептора проникает в клетку в составе везикулы: участок мембраны, к которому прикрепился аденовирус, впячивается в цитоплазму и затем отшнуровывается с образованием пузырька — эндосомы. В эндосоме вирус частично «раздевается», избавляясь от некоторых поверхностных элементов капсида, и его ДНК, прикрытая нуклеокапсидом, выходит из эндосомы и при участии микротрубочек направляется к клеточному ядру, в которое входит через ядерные поры. Окончательное освобождение аденовирусной ДНК происходит непосредственно у ядерной поры сразу перед перемещением вирусного генома в ядро, чтобы клеточные ферменты не смогли распознать и разрушить вирусную ДНК (O. Meier, U. F. Greber, 2004. Adenovirus endocytosis). После успешного «захвата» ядра вирусу необходимо переключить клетку на синтез компонентов новых вирусных частиц и репликацию вирусного генома. Экспрессия вирусных генов запускается не одновременно: часть активируется вскоре после проникновения в ядро (ранние гены), другие подключаются на более поздних стадиях инфекции (поздние гены). После сборки новых вирусных частиц клетка погибает, и новое поколение вирионов аденовируса выходит наружу (рис. 2).

Рис. 2. Основные стадии жизненного цикла аденовируса. Встреча аденовирусной частицы с клеткой происходит в два этапа: первичный контакт частица осуществляет с рецептором CAR, вторичный — с корецептором (интегрином). После этого вирусная частица интернализуется клеткой в ходе эндоцитоза в составе мембранного пузырька (эндосомы). Закисление внутренней среды эндосомы приводит к тому, что часть белков капсида диссоциирует, и вирусная ДНК в составе нуклеокапсида доставляется к ядерной поре. Через ядерную пору геном аденовируса попадает в ядро, где запускается экспрессия вирусных генов. Из новосинтезированных белков аденовируса и вирусной ДНК собираются новые вирусные частицы. Рисунок с сайта biologyreader.com
Ранее было показано, что аденовирусный белок VII обеспечивает упаковку генома вируса (M. A. Lischwe, M. T. Sung, 1977. A histone-like protein from adenovirus chromatin), а также взаимодействует с клеточным белком SET, функционирующим как гистоновый шаперон (то есть как погрузчик или, наоборот, разгрузчик молекул гистонов на ДНК, в том числе молекул линкерного гистона H1). Отмечено, что в хроматине клеток, экспрессирующих вирусный белок VII, содержится повышенное количество белка SET, а также белков группы HMGB (HMG-box). Авторы обсуждаемой работы смогли показать с помощью выделения клеточных белков и их последующей идентификации, что, наряду с увеличением количества белков SET и HMGB в хроматине клеток, инфицированных аденовирусом, падает количество линкерного гистона H1, который функционально противоположен белкам HMGB. Может ли вирус направленно вытеснять гистон H1 из хроматина при участии белков SET и HMGB и тем самым деконденсировать хроматин хозяйской клетки? Причастен ли к этому белок VII, который, как уже было показано, функционально связан с гистоновым шапероном SET?
Чтобы установить механизм влияния аденовируса на пространственную организацию генома клетки-хозяина, ученые экспрессировали белок VII в клетках дрожжей Saccharomyces cerevisiae и фиксировали все отличия этих клеток от нормальных клеток дрожжей. Ген, кодирующий белок VII, вводился в дрожжевые клетки в составе плазмид. Хроматин дрожжевых клеток во многих отношениях близок к хроматину клеток млекопитающих, но в целом их геном гораздо компактнее геномов животных и более прост в работе, поэтому для первых экспериментов авторы остановились на дрожжевой модели.
Оказалось, что экспрессия белка VII снижает скорость роста дрожжей на 40%, причем введение мутаций в функционально значимые участки белка VII восстанавливает нормальную скорость деления (рис. 3). Сам белок VII локализуется в ядре клетки и буквально покрывает клеточный геном, связываясь с хроматином на всем его протяжении. Таким образом, белок VII действительно напрямую взаимодействует с клеточным геномом, причем это взаимодействие в конечном счете приводит к остановке клеточного цикла и подавлению деления клеток. Авторы работы предположили, что белок VII может вытеснять линкерный гистон H1 при участии белков SET и HMGB.
Рис. 3. Белок VII аденовируса подавляет деление клеток дрожжей. Верхний ряд — клетки, экспрессирующие зеленый флуоресцентный белок (GFP) в качестве положительного контроля, второй ряд — клетки, экспрессирующие белок VII, нижний ряд — клетки, экспрессирующие белок VII с мутациями в позициях, которые делают его нефункциональным и восстанавливают нормальную скорость деления клеток. Числа внизу указывают на последовательные разведения исходной дрожжевой культуры: чем больше число, тем меньше дрожжевых клеток было высеяно. Рисунок из обсуждаемой статьи в Current Biology
Чтобы подтвердить эту гипотезу, ученые получили штаммы дрожжей, не имеющие гомологов белков SET или HMGB. Оказалось, что штаммы, лишенные гомологов SET, но экспрессирующие белок VII, растут примерно с той же скоростью, чем дрожжи дикого типа, или даже быстрее. Следовательно, устранение ключевого партнера белка VII — белка SET или его гомолога — восстанавливает нормальный клеточный цикл, несмотря на экспрессию белка VII.
Эксперименты на клетках человека показали, что экспрессия белка VII приводит к снижению количества молекул гистона H1 в составе хроматина, а в условиях in vitro белок VII прекрасно взаимодействует с человеческой ДНК. Напрашивается мысль, что белок VII обладает гистоноподобными свойствами и конкурирует с клеточным гистоном H1 за сайты связывания в хроматине. В этом нелегком деле белку VII могут помогать белки SET и HMGB, которые, взаимодействуя с ним, могут облегчать его включение в состав клеточного хроматина. А это, в свою очередь, нарушает нормальный клеточный цикл и подавляет клеточное деление.
Дрожжи S. cerevisiae размножаются путем почкования, поэтому за ходом клеточного цикла в клетках этих дрожжей можно наблюдать, оценивая динамику роста почек на материнских клетках. При экспрессии белка VII дрожжевые клетки демонстрируют видимые дефекты почкования, что свидетельствуют о глобальных нарушениях цикла. Экспрессия белка VII приводит к тому, что в популяции дрожжевых клеток резко возрастает доля клеток с большими почками, которым словно что-то мешает поделиться и довести клеточный цикл до конца. Со временем доля таких клеток увеличивается. Клетки с большими почками застревают или на переходе от фазы синтеза (S-фазы) к фазе G2 в пределах интерфазы, или на выходе из интерфазы в конце фазы G2. В обоих случаях нормальный митоз не происходит (рис. 4). Экспрессия белка VII в клетках пигментного эпителия человека также препятствует их нормальной пролиферации, причем в популяции возрастает доля клеток, застрявших на переходе от G2-фазы к митозу или в самом митозе. Иными словами, белок VII останавливает клеточный цикл. Любопытно, что «застрявшие» на пути к делению клетки не запускают программируемую гибель, хотя молекулярные механизмы этого явления остаются неясными.

Рис. 4. Белок VII увеличивает долю клеток с большими почками в популяции дрожжей по сравнению с нейтральным GFP, выбранным в качестве положительного контроля. На круговых диаграммах показаны доли клеток дрожжей трех фенотипов — без почки (none), с маленькой почкой (small) или с большой почкой (large) — в двух линиях дрожжей: экспрессирующих GFP (который никак не влияет на клеточный цикл) и экспрессирующих белок VII. Рисунок из обсуждаемой статьи в Current Biology
Стоит отметить, что в ходе жизненного цикла аденовируса одними из первых активируются гены, кодирующие белки E1A и E1B, которые, в отличие от более позднего белка VII, способствуют делению клеток. Как показали эксперименты на клетках линии эмбриональной почки HEK 293, экспрессирующих белки E1A и E1B, синтез белка VII перекрывает действие этих белков, способствующих пролиферации, и останавливает клеточный цикл. Таким образом, начало аденовирусной инфекции сопровождается экспрессией вирусных генов, продукты которых способствуют клеточному делению, чтобы запустить репликацию вирусной ДНК. Однако на поздних этапах инфекции, когда начинает синтезироваться белок VII, клеточный цикл останавливается, так как белок VII перекрывает действие белков E1A и E1B.
Исследование экспрессии генов в клетках HEK 293, экспрессирующих белок VII, показало, что в них накапливаются молекулярные маркеры поздней G2-фазы и митоза: циклин A2, фосфорилированная циклинзависимая киназа 1, тимидинкиназа, геминин, циклин B1, а также фосфорилированный по остатку серина 10 гистон H3. Все эти данные подтверждают гипотезу, согласно которой аденовирус на поздней стадии инфекции «взламывает» систему контроля клеточного цикла с помощью гистоноподобного белка VII и не дает инфицированным клеткам завершить клеточный цикл. Экспрессия белка VII приводит к тому, что белок HMGB1, до этого диффузно разбросанный по клеточному ядру, плотно облепляет хроматин (рис. 5). Остановка клеточного цикла позволяет вирусу полностью оприходовать клеточные ресурсы под свои нужды, прежде всего — направить их на сборку новых вирионов.

Рис. 5. Жизненный цикл аденовируса и изменения в хроматине клетки-хозяина. В незараженной клетке (серая, слева) линкерный гистон H1 участвует в компактизации хроматина, а белки SET и HMGB с хроматином не взаимодействуют. В начале инфекции (early infection) происходит экспрессия вирусных генов E1A и E1B, которые способствуют делению клетки. На поздних этапах инфекции начинается синтез белка VII, который при участии белков SET и HMGB вытесняет гистон H1, что приводит к разрыхлению хроматина и останавливает клеточный цикл. В конце концов клетка лизируется, высвобождая новосинтезированные вирусные частицы. Рисунок из обсуждаемой статьи в Current Biology
Примечательно, что, хотя человек и дрожжи разделены миллиардом лет эволюции, аденовирусный белок VII вызывает схожие изменения в их клетках. По всей вероятности, главная задача белка VII — подавить действие белков E1A и E1B, стимулирующих клеточное деление, и на поздних этапах инфекции сконцентрировать все клеточные ресурсы на сборке новых вирионов. Ведь если клетка поделится, то все усилия аденовируса по синтезу компонентов вириона пойдут прахом. В то же время на ранних этапах инфекции собственная аденовирусная ДНК должна удваиваться, чему и способствуют ранние белки E1A и E1B. Авторы исследования отмечают, что антагонизм гистона H1 и белков HMGB, вероятнее всего, является довольно древним регуляторным механизмом, который разнообразные патогены могут использовать в своих целях.
Источник: Kelsey L. Lynch, Melanie R. Dillon, Mongoljin Bat-Erdene, Hannah C. Lewis, Robin J. Kaai, Edward A. Arnold, Daphne C. Avgousti. A viral histone-like protein exploits antagonism between linker histones and HMGB proteins to obstruct the cell cycle // Current Biology. 2021. DOI: 10.1016/j.cub.2021.09.050.
Елизавета Минина
Живое по определению понижает энтропию, в то время как неживое ее не понижает.Гениально-чудовищно антинаучно!!!
Жизнь, как автокаталическая реакция, всегда ускоряет самопроизвольные процессы, то есть она ускоряет самопроизвольное увеличение энтропии.Чудовищно антинаучное утверждение, ваша персональная выдумка. Доказано что оно антинаучно, более того, данное утверждение было в категорическом смысле опровергнуто. Вы ничего не знаете из того что пишите, никогда ничего не знаете ни в одной теме по которой пишите свои фантазии. Жизнь не определяется как автокатолическая реакция, автокатолических реакций бесконечное количество и к жизни они не относятся. Уверен, что вы понятие не имеете что такое энтропия, это сразу понятно.
Доказано, что жизнь уменьшает энтропию своей системыУважаемый Гений, жизнь существует только в неравновесных системах, и только за счет ускорения роста энтропии в таких системах.
https://ru.wikipedia.org/wiki/Второе_начаДавно не читал эту статью. В самом конце там написано:ло_термодинамики#Второе_начало_термодинамики_и_критика_эволю ционизма.
"Несмотря на (1)«локальное» уменьшение энтропии путем «упорядоченных» процессов, (2)происходит суммарное увеличение энтропии вселенной, а живые организмы являются в некотором роде катализаторами этого процесса."Да, второе это мнение, хотя и никем не доказанное. Первое утверждение является фактом, а второе является предположением. Верность второго предположения ничего не меняет, поскольку по нему энтропия увеличивается там где жизни нет, а в системе где есть жизнь энтропия всегда уменьшается.
Первое утверждение является фактом, а второе является предположением.Удивительно причудливо сознание у гениев.
энтропия увеличивается там где жизни нет, а в системе где есть жизнь энтропия всегда уменьшаетсяЭто миф, основанный на вере. Спорить с ним бессмысленно.
Неужели вы хотите сказать что прионы живые?Я уже ответил на этот вопрос:
это древний холивар. Он только подтверждает неопределенность самого понятия жизнь
Сначала дают ссылку на публикацию, а потом оспаривают ее достоверность:)Это не правда, я сразу вам написал это еще до того как дал ссылку, удивительна ваша неспособность читать, сразу видно что вы принадлежите поколению гугл. Вот мой текст об этом же:
Энтропия системы уменьшается, но считается что поскольку система в которой существует жизнь не замкнута, то к ней не возможно применить второе начало термодинамики, и дескать ничего не нарушается, дескать вне системы в которой существует жизнь все равно энтропия растет, то есть общая термодинамическая энтропия вселенной увеличивается, но именно что вне жизни, хотя сам этот рост суммарный энтропии при этом никем не доказан. Но однозначно что энтропия в системе где находится жизнь падает, даже термодинамическая.но вы его видимо проигнорировали.
Это миф, основанный на вере. Спорить с ним бессмысленно.Миф это ваша выдуманная лично вами антианучная выдумка в которую вы верите потому что неспособны воспринимать информацию. Удивительная ваша способность читать одно и тут же игнорировать это и утверждать другое, прямо противоположное научным фактам.
Во-первых любой зеленый листик, любая циан-бактерия в водах океана, сокращает время жизни фотонов, излучаемых солнцем.Ерунда, поскольку АТФ на колоссально много больше понижает энтропию чем существование фотона. Фотон же всё равно исчезнет, потому что его поглотит если не жизнь, то мертвая земля.
Во-вторых самая продвинутая форма жизни разлагает в своих реакторах уран, который мог спокойно распадаться еще миллиарды лет. При этом, в конечном счете превращает ядерную энергию в тепло, которое рассеивается в мировом пространстве.Ерунда, поскольку строительство домов на колоссально много больше понижает энтропию чем существование радиации. Радиация это увеличение энтропии, поскольку разрушает атомы. Уран лежа в земле только увеличивает энтропию, поскольку разрушаются атомы.
В-третьих. Вы вдыхаете кислород, а выдыхать норовите всякую гадость:)Чушь, энтропия кислорода больше чем энтропия углекислого газа, но никак не меньше.
В-четвертых. До появления грибов, типа опенка, стволы погибших деревьев не разлогались, и могли спокойно окаменеть.Ничего не значит, то есть абсолютно. Точнее показывает, что с развитием жизни энтропия уменьшается еще стремительнее за счет самосохранения и большей переработки энергии.
В-пятых. В результате появления навозных мух, какашки стали быстро разлагаться. А это препятствует образованию капролитов.То есть энтропия стала уменьшаться еще стремительнее.
В-шестых. При желании найдете еще массу примеров. Там где нет жизни, например на Луне, изменения, которые в силу необратимости ведут к росту энтропии, происходят очень медленно.Там где есть жизнь энтропия стремительно падает, просто очень быстро. Живая клетка пример жестко упорядоченной системы с постоянно уменьшающейся энтропией - это доказано просто как дважды два.
Он только подтверждает неопределенность самого понятия жизньЭто доказывает что вы не способны ответить на вопрос и признать свою неправоту, принципиально.
Любая переработка энергии в структуры уменьшает энтропию, такова математика.Вы решили опровергнуть второй закон термодинамики?
Чушь, энтропия кислорода больше чем энтропия углекислого газа, но никак не меньше.У меня нет слов. Спорить с Вами бесполезно.
Локальное понижение энтропии в неравновесной системе происходит сплошь и рядом, начиная от ячеек Бенара и кончая лазерами. Это не исключительное свойство жизни, как Вы ее понимаете.Еще раз повторяю, вы читать не умете. А читая не видите что читаете. Вот что я писал в отличии от вас что приписывает мне то, что я не утверждал:
Жизнь по определению это понижение энтропии системы за счет самосохранения и саморазмножения.Где у ячеек Бенара и лазеров саморазмножение и самосохранение? Так что вы опровергнуты в очередной раз. Слово "понижение" это именно выражение целенаправленного неслучайного процесса снижения энтропии который именно выражает жизнь. Локальное снижение у неживого энтропии это случайное состояние, недолговечное и бесцельное, оно не распространяется, то есть это скачек энтропии в низ, а не ее понижение, а у живого это именно цель - понизить энтропию системы и расширить это понижение энтропии, более того лазеры это дело рук человека, то есть снижение энтропии руками живого человека.
Вы решили опровергнуть второй закон термодинамики?Учитесь, закончите школу. Более того вы сами противоречите себе , только что вы написали утверждение где вы отрицаете второе начало термодинамики
Локальное понижение энтропии в неравновесной системе происходит сплошь и рядом, начиная от ячеек Бенара и кончая лазерами.....
Дальше читать не стал. Слишком много букв, и слишком сильно потрясение.Вы ничего не способны прочитать, ни один текст не дочитали до конца ни из одного источника. Поэтому принципиально неспособны ничего понять. Это очень смешно, вы написали огромное количество бессмысленных букв в которых нет содержания, одни ошибочные утверждения, а опровержение его ошибок для него это видите ли слишком много букв.
У меня нет слов. Спорить с Вами бесполезно.Да потому что я прав, а вы неправы, но признать свою неправоту неспособны, аргументы классической науки для вас недоступны.
И живое, и не живое, и вирусы, и белки самособираются.Совершенно не так. Вирусы не самособираются! Они на это не способны. Ни один вирус не может воспроизвести себя сам! Белки не самособираются! Они на это не способны. Ни один белок не может воспроизвести себя сам!




Рис. 1. Слева — трехмерная модель вириона аденовируса. Справа — его строение в разрезе. Гистоноподобный белок VII (оранжевые кружочки) в составе вириона упаковывает вирусную ДНК. Рисунки с сайта и из статьи M. Benevento et al., 2014. Adenovirus composition, proteolysis, and disassembly studied by in-depth qualitative and quantitative proteomics